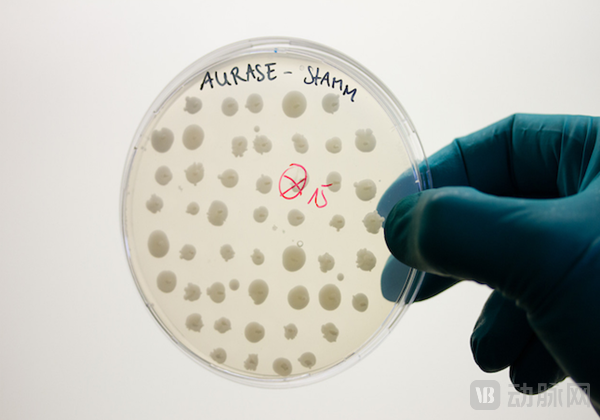
Thought Leadership image SolasCure.png

近日,英国剑桥的生物技术公司SolasCure完成了1090万英镑的B轮投资。本轮融资由Seneca Partners牵头,BRAIN Biotech AG(Xetra:BNN)、Abcam创始人Jonathan Milner博士跟投。

SolasCure融资历史
动脉网整理制作
SolasCure成立于2017年,是德国生物技术公司BRAIN Biotech AG的子公司。该公司基于仿生学和循证医学为慢性伤口愈合开发治疗药物。
伤口愈合缓慢被称为无声的流行病。据美国国立卫生研究院(National Institutes of Health,NIH)统计,发达国家中有1%-2%的人会在一生中会遭受慢性伤口的伤害。
本轮所融资金将用于SolasCure的Aurase®伤口敷料凝胶的开发以及创新伤口清创酶的II期临床试验开展。与正在进行的IIa期安全性研究相比,下一阶段的试验将涵盖数量更多,病情更多样化的患者。
伤口愈合本身是一个复杂但有序进行的生物学过程,但如果患者存在潜在的慢性疾病,身体自我修复能力受损,伤口就会难以自行愈合。因此,当伤口开放超过4-8周就会被诊断为慢性伤口(CNHW,Chronic Nonhealing Wounds)
根据伤口治疗的TIME原则:组织清创是治疗的第一步,也是最关键的一步,是控制伤口感染和水分平衡的先决条件。
随着全球人口老龄化、心脏病、糖尿病和肥胖症患者人的持续增长,继而造成的感染问题。CNHW已成为一项重大的临床、社会和经济的挑战。根据CDC(美国疾病控制与预防中心)的数据显示,2020年大约有9-12万美国人患有下肢慢性伤口或无法愈合的溃疡。
自然界自古以来都是人类各种技术思想的灵感源泉,大自然对于伤口清创早有自己的办法,蛆虫治疗早在9世纪就开始被医生使用,但抗生素的出现使得这种自然生物疗法逐渐淡出了人们视野。直到抗生素的滥用引发耐药性,又让这个古老的疗法重新回到了临床治疗视野。而仿生学则是自然与生物技术连接作为桥梁。
与之前的活虫的“土方法”不同,SolasCure利用仿生学和循证医学的方法将蛆虫疗法的靶向疗效与水凝胶的便利性相结合,旨在改善清创过程,适用于医院、疗养院或家庭护理等多种伤口护理环境。
BRAIN Biotech AG借助“自然工具箱”开发出了一种新型酶,并发现这种酶可以用于CNHW的生物治疗。为了加强其业务增长,BRAIN Biotech AG投资成立子公司SolasCure,将此项专利移交给SolasCure继续开发这款药物,包括未来的CE认证及商业化。
SolasCure在BRAIN Biotech AG的初步研究的基础上开发了第一款产品Aurase®伤口凝胶敷料,该药物的有效成分便是这种新型生物酶,而这种酶最初是来自于蛆的唾液。
这种蛆是丝光绿蝇(Lucilia Sericata Meigen)的幼虫。丝光绿蝇和它的幼虫蛆给人的传统印象十分肮脏,但与刻板印象不同的是,丝光绿蝇的蛆其实只食用伤口中死亡和垂死的组织,留下一个干净的伤口来愈合。
如何安全、有效的在患者伤口使用医用蛆是个巨大的难题。医用蛆是一套复杂的医疗工具,蛆虫的无菌饲养、运输和使用需要经验丰富的护理人员和复杂的基础设施帮助,并且医用蛆通常会造成伤口护理人员和患者的心理反感,不利于治疗的延续性。
Aurase实验
图源:SolasCure官网
为了解决使用途径和方式的难题,SolasCure将蛆唾液中的蛋白水解酶进行仿生学的基因克隆。首先对蛆产生该酶的基因进行测序,然后将其克隆到Pichia酵母中进行增殖,由此产生足够规模的重组酶。最后,将这种新型蛋白水解酶添加到水凝胶中,保障新型酶的活性的同时使护理人员以及患者易于使用。
水凝胶敷料形式的Aurase®使护理人员仅仅用刮板就可以将其直接涂抹在伤口处,然后贴上隔断贴。敷料和隔断贴形成了暂时性皮肤屏障,避免或控制伤口感染,提供有利的修复环境,促进创面愈合。蛆衍生蛋白水解酶就可自行分解伤口的坏死组织,并且该成分一旦进入患者体循环中就会迅速失活,避免药物对患者机体健康造成影响。

Aurase
图源:SolasCure官网
此外,相比于通过刀等锐器多次去除坏死组织的手术清创,以及水流冲洗、器械搔刮的物理清创的操作难度及二次伤害,敷料的方式让患者伤口的护理更加便捷。无论是在医院还是家中,患者都可以使用Aurase®改善预后,避免了长期不适、虚弱的患者因为慢性伤口反复前往医疗机构,从而降低了患者的整体治疗成本以及身体疼痛。
2021年,SolasCure在英国医疗和保健产品监管局(MHRA)授权下,开始了Aurase®Wound Ge的IIa期临床试验。同年,该产品获得FDA的IND批准。目前该试验涉及英国,美国和匈牙利的多个医疗研究中心。

Aurase研发管线
图源:SolasCure官网
据SolasCure官网获悉,该临床试验的结果将于2023年公布。
今年1月,SolasCure在《国际伤口杂志》(International Wound Journal)发布了Aurase®的临床前试验结果,结果表明新型重组蛋白水解酶可用于局部或全身的清创,并且不会阻碍伤口的愈合,无致敏性,结果数据展现出了良好的安全性和有效性。
根据市场调研机构Fortune Business Insights的数据显示,全球慢性伤口护理市场预计将从2022年的123.6亿美元增长到2029年的195.2亿美元,预测期内的复合年增长率为6.7%。
创新是Aurase®从生物实验向生物经济转型的关键,也是企业发展的驱动力。Aurase®为慢性伤口治疗提供了新颖的解决方案和经济价值。面对如此大的慢性伤口护理市场,如何尽快通过临床试验获得批准,成功推进商业化是SolasCure需要面对的难题。
SolasCure的创始人兼CEO Sam Bakri拥有伦敦大学学院(Univesity College London, UCL)医学博士学位以及哈佛大学商学院的MBA。

Sam Bakri
图源:SolasCure官网
作为一名连续创业者,Sam Bakri博士在生命科学行业工作了20多年,曾担任Gelmetix、AIDA Health、Gelmetix Healthcare和Kind Consumer的联合创始人及CEO。Sam Bakri还是美国妙佑诊所(Mayo Clinic)的常驻企业家和约翰·霍普金斯大学凯里商学院的教员。
作为一名专注于医疗健康领域的国际创业者,BRAIN Biotech AG关于Aurase的研究引起了Sam Bakri的兴趣。于是在BRAIN Biotech AG的支持下,Sam Bakri于2017年创立了SolasCure。
SolasCure的首席医疗官David Goldsmith曾担任伦敦大学学院心肾医学教授,现为荣誉教授。拥有30年临床医学经验,他在临床试验的监督和管理方面拥有丰富经验。David Goldsmith的h-index在2021年达到了73,具有极高的学术影响力。
首席技术官Bela Kelety拥有德国达姆施塔特工业大学的化学硕士学位以及马克斯普朗克学会(Max-Planck-Institut,MPI)生物物理研究所的博士学位。自1992年以来Bela Kelety一直从事生物技术领域的相关工作,曾担任BRAIN Biotech AG的战略项目经理。
SolasCure目前已在多平台获得认可。2022年,SolasCure在EIT Health Catapult中获得生物技术组的冠军。Catapult竞赛在欧盟委员会的支持下创办,旨在帮助创新公司提升知名度和曝光度,促进其创新解决办法用以改善欧洲患者和公民生活。
2023年2月,SolasCure还被英国商务贸易部(Department for Business and Trade)选为2023 UK Life Sciences Innovator(生命科学创新者)。


















